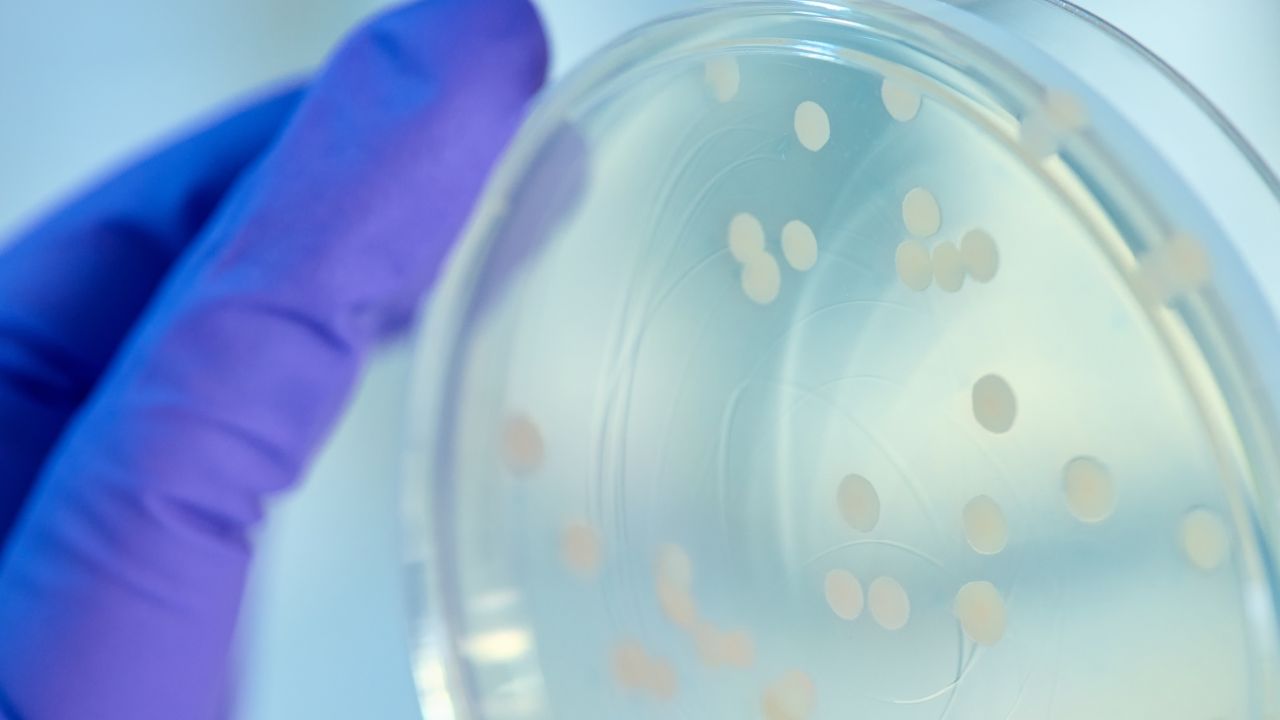
Microbiologics lab in St. Cloud

Minnesota is an Industry Leader

From advanced manufacturing and life sciences to agriculture and clean technology, Minnesota is home to businesses as diverse as our workforce.
Join leaders like 3M, Cargill, Polaris, and Medtronic in the Star of the North.
Advanced Manufacturing
Minnesota’s manufacturing sector is the backbone of the state’s economy, representing 13% of the state’s GDP and more than $22 billion in manufactured exports annually (2023). Minnesota's diverse, technology-driven advanced manufacturing sector is particularly strong in high-tech manufacturing, including computers and electronics, medical devices, and vehicles.
“You want to be manufacturing semiconductors in a place like Minnesota because of the stable infrastructure.
You've got high-quality power, access to water — it's easy to get goods in and out.”
— Mike Rital, Chief Financial Officer, Polar Semiconductor
Clean Tech & Renewable Energy
Minnesota ranks among the top states for environmental friendliness and sustainability practices and has thriving companies in a broad range of clean technology and renewable energy clusters, including biofuels, water technology, and wind and solar power. As the first state to mandate the use of biofuels in 2005, Minnesota has seen carbon emissions from the power sector decline by 40% in the last 10 years and 10% in the previous year alone.
Additionally, the state boasts a robust smart mobility infrastructure and industry leaders developing new technologies in sustainable transportation methods.
By the Numbers
- Companies in Minnesota: 17,066
- State GDP Contribution: $39.7 billion, or 8.4%
- Exported Goods: $4.7 billion (Trade Data Monitor)
- Sector Employment: 200,164
Source: Unless noted otherwise, all data from Lightcast (2023)
Our Rankings

Sources: U.S. News & World Report, U.S. News & World Report, American Council for an Energy-Efficient Economy.
“We are building the future of renewable energy in Minnesota.”
— William, Project Manager, Blattner Energy
Food Production & Agriculture
Minnesota is a food production and agricultural powerhouse. The state ranks fourth in the nation in the total value of crops and fourth in agricultural exports, making it one of the top producers of food in the country.
Not surprisingly, Minnesota is home to global leaders in agriculture food production and distribution, including the nation’s largest privately held company, Cargill.
By the Numbers
- Companies in Minnesota: 5,163
- State GDP Contribution: $20.9 billion, or 4.4%
- Exported Goods: $10.0 billion (USDA, 2022)
- Sector Employment: 123,897 workers
Source: Unless noted otherwise, all data from Lightcast (2023)
Our Rankings

Life Sciences
Home to the country's top-rated hospital (Mayo Clinic) and largest health insurer (UnitedHealth Group), Minnesota is committed to supporting the life sciences. In “Medical Alley,” businesses have access to an ecosystem of public, private, and non-profit partners focused on passionate collaboration and innovation for the greater good.
By the Numbers
- Companies in Minnesota: 7,407
- State GDP Contribution: $48.5 billion, or 10.3%
- Exported Goods: $3.8 billion (Trade Data Monitor)
- Sector Employment: 326,301 workers
Source: Unless noted otherwise, all data from Lightcast (2023)
“Medical Alley is an organization [that] brings together all components of the healthcare system — providers, payers, service providers, equipment manufacturers, medical device therapies, etc.
It's one of the few places where you can find all those constituents leaning in to solve problems across healthcare.”
— Jim Rogers, Chief Business Development Officer, Mayo Clinic
Technology
Minnesota has long been home to technology companies that transform the world for the better. Key to Minnesota’s success is our tech-savvy workforce and a thriving innovation ecosystem of higher education institutions, R&D, and public-private partnerships.
By the Numbers
- Companies in Minnesota: 15,364
- State GDP Contribution: $26.5 billion, or 5.6%
- Exported Goods: $4.9 billion (Trade Data Monitor)
- Sector Employment: 129,673 workers
Source: Unless noted otherwise, all data from Lightcast (2023)
Our Rankings

Source: Lightcast, Milken Institute, Yahoo! Finance
“Rosemount, [Minnesota] stood out as an outstanding location for our newest data center thanks to its great access to infrastructure, deep pool of talent, and amazing community partners.”
– Brad Davis, Director of Data Center Community and Economic Development, Meta